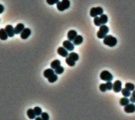
Cette bactérie qui survit en salle blanche

Les réactions chimiques sont un moteur pour l’industrie. En effet, les grandes évolutions techniques sont le résultat d’une maîtrise de ces procédés.
Les biotechnologies sont des procédés qui ont recours à l’utilisation ou à la transformation de matériaux vivants. Elles se déclinent également dans d’autres domaines comme la biotechnologie végétale et la biotechnologie santé. De plus, l’ingénierie, la chimie ou la pharma exploitent des procédés de biotechnologie simples au plus complexes.
L’actualité scientifique nous rappelle que le secteur pharmaceutique, celui de la chimie organique ou encore de la chimie analytique bénéficient souvent des avancées des biotechnologies pour prévenir, notamment, des problématiques sécuritaires.
Face à l’intensification des procédés et des ressources de plus en plus difficiles à exploiter, la chimie s’adapte à de nouveaux enjeux comme la chimie verte.